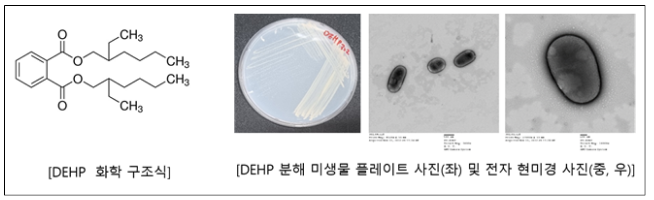

플라스틱 가소제 분해능력 뛰어난 담수 미생물 5종 발견 2022.12.25 환경부 플라스틱 가소제 분해능력 뛰어난 담수 미생물 5종 발견 - 국립낙동강생물자원관, 분해 최적화 연구를 통해 특허 출원 예정 - 환경부 산하 국립낙동강생물자원관(관장 유호)은 구미 공단에 인접한 광평천에서 채취한 시료에서 플라스틱 가소제인 디에틸헥실프탈레이트* 분해능력이 우수한 담수 미생물 5종을 최근 발견했다고 밝혔다. * 가장 대표적인 프탈레이트 계열 플라스틱 가소제(可塑劑)로 비닐, 포장재, 의약품 등 다양한 제품 생산에 사용되는 무색⋅무취의 화학물질 이들 담수 미생물은 디에틸헥실프탈레이트를 분해하면서 생성되는 물질을 성장에 필요한 영양원으로 이용하는 호기성(好氣性) 세균*이다. * 공기 또는 산소(O2)가 존재하는 조건에서 영양소를 분해⋅활용하여 세포호흡을 할 수 있는 미생물의 일종 국립낙동강생물자원관 연구진은 올해 3월부터 12월 사이에 구미 광평천에서 채취한 시료(하천수, 퇴적토)로부터 디...
#국립낙동강생물자원관
#담수미생물
#분해최적화연구를통해특허출원예정
#플라스틱가소제분해능력
#환경부
원문링크 : 플라스틱 가소제 분해능력 뛰어난 담수 미생물 5종 발견_환경부






